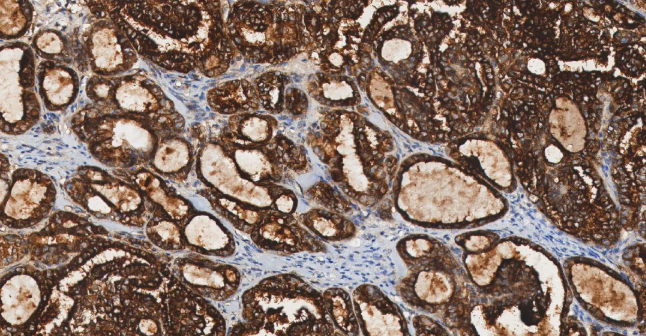
人卵巢癌组织的 FOLR1 免疫组化分析

免疫组织化学IHC检测肿瘤标志物
免疫组织化学 (IHC) 通过抗原-抗体反应对组织切片中的特定蛋白进行原位示踪,是当代病理诊断的基石技术。在肿瘤学领域,IHC 检测肿瘤标志物,已成为现代病理诊断与研究不可或缺的工具......
Section.01 肺癌标志物
PD-L1
PD-L1——免疫检查点分子,属于 B7-CD28 免疫调节超家族。
• 定位:细胞膜。
• 功能:PD-L1 是一种跨膜蛋白。其主要生理功能是在免疫突触中与免疫 T 细胞表面的 PD-1 受体结合,传递抑制性信号,通过抑制 T 细胞活化和增殖来发挥作用。
肿瘤细胞或肿瘤微环境中的免疫细胞会高表达 PD-L1,与浸润 T 细胞的 PD-1 结合,从而“关停” T 细胞的杀伤功能,实现免疫逃逸。在非小细胞肺癌中,PD-L1 的表达水平是预测免疫检查点抑制剂疗效的关键生物标志物。

图 1. 人肺癌组织的 PD-L1 免疫组化分析。
TTF-1
TTF-1——甲状腺转录因子-1,属于 NKX2 转录因子家族。
• 定位:细胞核。
• 功能:TTF-1 是调控肺组织和甲状腺器官特异性基因表达的核转录因子,对肺泡上皮细胞的终末分化和表面活性物质的分泌至关重要。
TTF-1 是关键的核转录因子,表达具有高度组织特异性。它在肺腺癌和甲状腺癌中高表达,是诊断这些原发癌的核心标志物[3]。其临床价值在于鉴别转移癌的原发部位:若 TTF-1 阳性,强烈提示肿瘤来源于肺或甲状腺。值得注意的是,肺鳞癌中 TTF-1 通常为阴性,需结合其他标志物来进一步确认。

图 2.人肺癌组织的 TTF-1 免疫组化分析。
MET
MET——MET 基因是定位在人类第 7 号染色体上的一个原癌基因,其编码生成的 c-Met 蛋白属于受体酪氨酸激酶家族。
• 定位:细胞膜。
• 功能:MET 是肝细胞生长因子 (HGF) 的受体。正常的 HGF/MET 信号通路精密调控胚胎发育、组织再生和损伤修复过程中的细胞增殖、分化和迁移。
在肺癌中,MET 可通过基因扩增、蛋白过表达或 14 号外显子 (METex14) 跳跃突变等方式异常激活,导致下游促生长和生存信号通路持续活化,驱动肺癌的生长、存活和转移。MET 扩增/过表达是 EGFR 靶向治疗获得性耐药的重要机制之一。

图 3.人肺癌组织的 MET 免疫组化分析。
Section.02 乳腺癌标志物
ERα
ERα——雌激素受体,属于核激素受体超家族。
• 定位:细胞核。
• 功能:雌激素受体是一种位于细胞核内的配体依赖性转录因子。当雌激素与其结合后,受体被激活,进而调控与细胞增殖、分化相关的靶基因转录,主导女性第二性征发育,并参与月经周期中乳腺和子宫内膜的生理性变化。
Carol E DeSantis 等在 2019 年统计,雌激素受体 α 阳性 (ERα+) 乳腺癌占全球报告病例的 79%。这类癌细胞的生长高度依赖雌激素信号通路。ER 阳性状态是乳腺癌预后相对较好的重要指标,也是选择内分泌治疗的直接靶点。

图 4.人乳腺癌组织的 ERα 免疫组化分析。
PR
PR——孕激素受体,属于核激素受体超家族。
• 定位:细胞核。
• 功能:孕激素受体是一种核内转录因子,当与孕激素结合后,主要调控子宫内膜向分泌期转化及平衡雌激素驱动的乳腺增生。
PR 表达依赖完整 ER 信号通路。在 ER 阳性的乳腺癌中,PR 阳性进一步证实了激素信号通路的活跃性,是预测内分泌治疗反应性的重要辅助指标,通常与更好的预后和更高的内分泌治疗有效率相关[8]。

图 5. 人乳腺癌组织的 PR 免疫组化分析。
HER2
HER2——人表皮生长因子受体 2,属于表皮生长因子受体家族。
• 定位:细胞膜。
• 功能:HER2 是一种具有酪氨酸激酶活性的跨膜蛋白,但无已知配体。它通常与其他家族成员形成异二聚体,参与传递调控细胞生长和分化的信号[9]。
大约 20-30% 的乳腺癌存在 HER2 基因扩增,从而使细胞膜上 HER2 蛋白的显著过表达。这引发强烈的、持续的下游促增殖信号,导致侵袭性更强的肿瘤表型[10]。此外,HER2 的过表达或突变与胃癌、胃食管癌、肺癌、子宫内膜癌及卵巢癌也密切相关。

图 6. 人乳腺癌组织的 HER2 免疫组化分析。
Ki-67
Ki-67——细胞增殖相关的标志性蛋白。
• 定位:细胞核
• 功能:Ki-67 是重要的细胞增殖标志物。它标记处于活跃细胞周期 (G1、S、G2和 M 期) 的细胞核,其表达指数 (阳性细胞百分比) 直接反映肿瘤的增殖活性和生长速度。

图 7. Ki-67 在整个细胞周期中的定位。
KI-67 是评估癌细胞增殖活性的通用标志物,与所有需评估增殖活性的癌症均相关。在乳腺癌中,它是区分 Luminal A 型和 B 型亚型的关键参数之一。

图 8. 人乳腺癌组织的 Ki67 免疫组化分析。
Section.03 结直肠癌标志物
CDX2
CDX2——尾型同源框转录因子 2,属于尾型同源盒转录因子家族。
• 定位:细胞核。
• 功能:CDX2 是肠上皮细胞分化和功能维持的关键转录因子,调控众多肠道特异性基因的表达。
CDX2 在结直肠癌中普遍表达,是确诊肠源性肿瘤的首选标志物。CDX2 具有诊断和预后两方面的意义。一方面它有助于鉴别原发灶不明的转移癌,另一方面在结直肠癌中,其表达状态与分子亚型和预后相关。

图 9. 结直肠癌患者 CDX2 免疫染色结果。
SATB2
SATB2——SATB 家族蛋白 2,属于特殊 AT 序列结合转录因子家族。
• 定位:细胞核
• 功能:SATB2 是调控基因表达和细胞分化的核转录因子,在结直肠癌和骨源性肿瘤的病理诊断中,是一个高度特异性的标志物。
SATB2 在大多数肿瘤中表达量都很高,常与其他靶点联合使用,作为癌症的诊断和预后生物标志物。结直肠癌中,SATB2 的表达具有极高的特异性,其诊断特异性甚至高于 CDX2。在诊断结直肠癌时,SATB2 与 CDX2 联合阳性具有极高的特异性,是目前最可靠的组合之一。

图 10. 结直肠癌患者 SATB2 免疫染色结果。
Section.04 前列腺癌标志物
PSA
PSA——前列腺特异性抗原,属于人组织激肽释放酶 (KLK) 家族。
• 定位:PSA 主要位于前列腺腺上皮细胞的细胞质中,属于分泌型蛋白。
• 功能:PSA 是一种由前列腺上皮细胞分泌的丝氨酸蛋白酶,其正常生理功能是液化精液。
PSA 是前列腺癌最经典的血清学及组织学标志物。当前列腺组织的结构被破坏时,PSA 会大量泄漏入血,导致血清 PSA 水平升高。因此,血清 PSA 检测被广泛用于前列腺癌的早期筛查、风险评估和疗效监测。

图 11. 人前列腺癌组织的 PSA 免疫组化分析 。
PSMA
PSMA——前列腺特异性膜抗原,属于 II 型跨膜糖蛋白家族,在功能上属于谷氨酸羧肽酶家族。
• 定位:PSMA 是跨膜蛋白,主要定位于前列腺癌细胞的细胞膜,尤其是细胞与细胞之间相互接触的区域,胞内部分也存在于细胞质。
• 功能:PSMA 是一种 II 型跨膜锌金属蛋白酶,具有叶酸水解酶活性,参与细胞代谢和信号传导。
PSMA 在前列腺癌细胞上的表达量是正常前列腺的 100 到 1000 倍。这一特性使其超越了单纯的诊断标志物,成为了“诊疗一体化”靶点。

图 12. 人前列腺癌组织的 PSMA 免疫组化分析。
AMACR
AMACR——α-甲基酰基辅酶 A 消旋酶。
• 定位:AMACR 主要位于细胞质,在癌细胞中可表现为颗粒状或弥漫性胞浆染色。
• 功能:AMACR 是一种线粒体和过氧化物酶体酶,参与支链脂肪酸和胆汁酸的 β-氧化代谢过程。
AMACR 是诊断前列腺癌的关键“阳性”标志物。它在绝大多数前列腺癌 (尤其是腺癌) 的癌细胞中会过表达,而在良性前列腺组织中表达很低或阴性。它常与 p63 等基底细胞标志物 (阴性标记) 联合使用,形成“一阳一阴”的诊断模式,极大提高了前列腺穿刺活检诊断的准确性。

图 13. AMACR 蛋白在不同前列腺病变中表达的免疫组化分析。
Section.04卵巢癌标志物
PAX8
PAX8——配对盒基因 8,是配对盒转录因子家族的核心成员。
• 定位:细胞核。
• 功能:PAX8 调控甲状腺、肾脏及苗勒氏管等器官的胚胎发育与细胞分化。
PAX8 在大多数卵巢肿瘤中表达,是诊断卵巢癌的关键核转录因子。它在卵巢高级别浆液性癌和子宫内膜样癌中高度特异性表达,是确定肿瘤来源于卵巢上皮 (特别是苗勒氏管系统) 的核心标志物,常用于鉴别卵巢原发癌与胃肠道等其他部位的转移癌。

图 14. 卵巢癌组织的 PAX8 免疫组化分析。
WT-1
WT-1——Wilms 肿瘤蛋白 1,属于锌指转录因子家族。功能上讲,也常被归类于早期生长反应 (EGR) 相关的转录因子家族。
• 定位:细胞核。
• 功能:在胚胎期作为关键转录因子,精密调控肾脏、性腺等泌尿生殖系统器官的形成与分化。
在卵巢癌中表达具有亚型特异性。在多达 64% 的浆液性卵巢癌中高度表达,是高级别浆液性卵巢癌的敏感且特异性的生物学标志物。而子宫内膜样癌、透明细胞癌和黏液性癌通常阴性,是病理分型的重要辅助标志物。

图 15. 卵巢癌组织的 WT-1 免疫组化分析。
FOLR1
FOLR1——叶酸受体 1,属于叶酸受体家族。
• 定位:细胞膜。
• 功能:在正常组织中主要负责转运叶酸,以维持机体代谢与发育需求。
FOLR1 的过度表达通常与癌症进展加快和患者预后较差有关。在多种实体瘤 (尤其是高级别浆液性卵巢癌、肺腺癌) 中异常高表达,而在正常组织表达受限,因此是备受关注的肿瘤靶向治疗和诊断显像的靶点。
图 16. 人卵巢癌组织的 FOLR1 免疫组化分析。
Section.05 小结
好啦,今天关于肿瘤标志物就先介绍到这里了——MCE 提供大量肿瘤标志物抗体,小伙伴还需要注意:每一个肿瘤标志物,都不是孤立的“判决书”,一定要结合多种检测指标联合判断,才能更准确。如果大家对其他标志物感兴趣,欢迎留言评论,咱们再接着聊!!

2026-03-23
MCE

